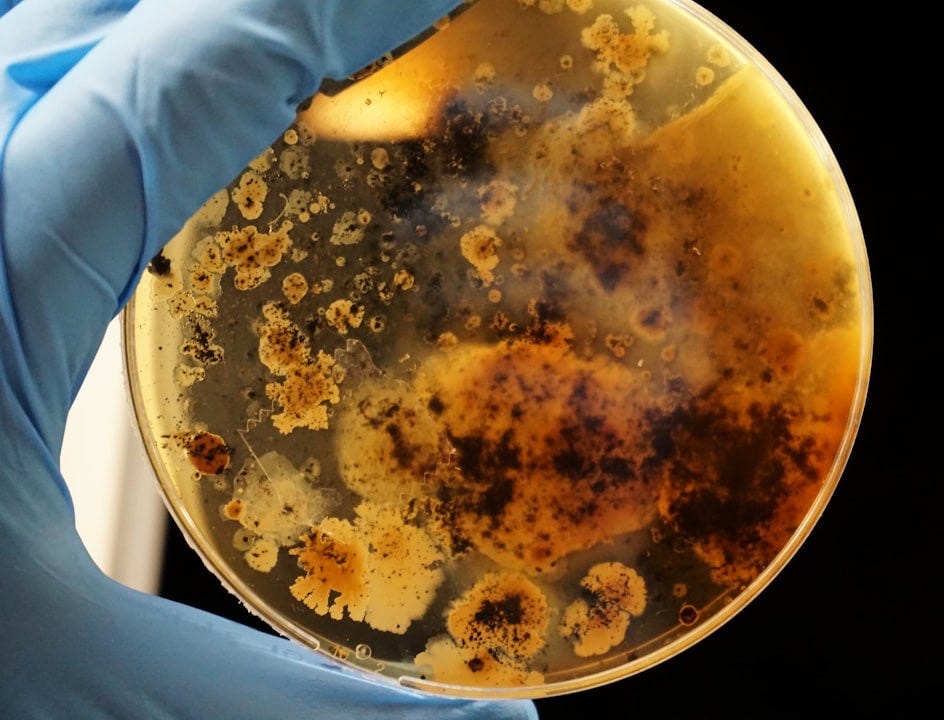
person in white long sleeve shirt holding blue ceramic plate with brown soup

Good guesses about why we and other people feel the way we feel and why we and other people do what we do are good hypotheses. How do we test our hypotheses to see if we’re right?
Experiments.
So how do you turn a good guess into an experiment?
You answer this question:
“What are you willing to do about it?”
Allow me to break…


